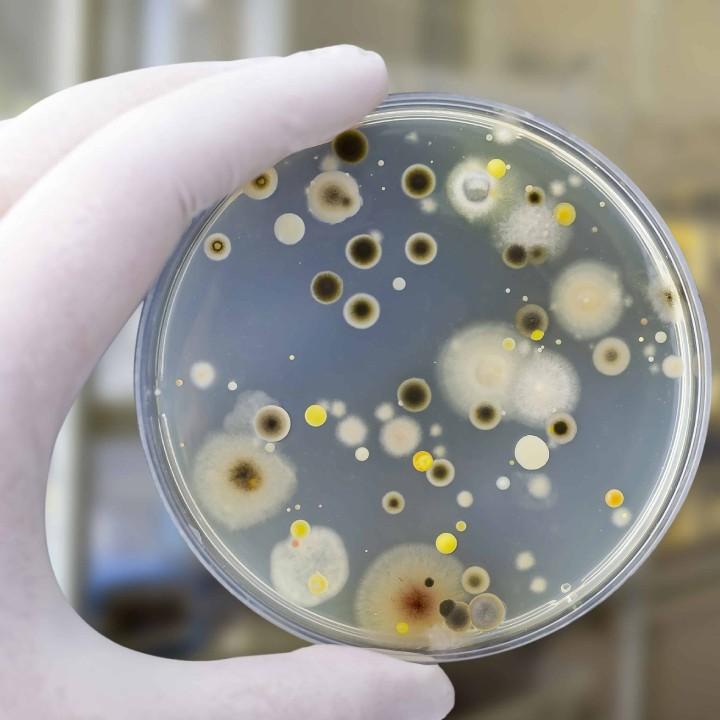

Exposure to mold can pose various health risks, and the immediate health dangers of mold can vary depending on factors such as the type of mold, the extent of exposure, and an individual’s sensitivity. Some people are more sensitive to mold than others, and certain individuals with allergies or respiratory conditions may be more vulnerable.


Fungal infections are more common and severe in individuals with compromised immune systems because the immune system plays a crucial role in defending the body against infections, including those caused by fungi. When the immune system is weakened or suppressed, as is the case in conditions such as HIV/AIDS, cancer, or during immunosuppressive treatments, the body becomes more susceptible to opportunistic infections, including fungal infections


Mold can cause skin irritation through direct contact with mold or mold-contaminated surfaces. While skin irritation is not as common as respiratory symptoms or allergic reactions, some individuals may develop skin problems when they come into contact with certain types of mold

Mold spores can exacerbate respiratory issues in individuals with pre-existing conditions like asthma through several mechanisms
The frequency of allergic reactions to mold spores can vary widely among individuals and is influenced by factors such as sensitivity, overall health, and the type and amount of mold present. Not everyone exposed to mold will experience allergic reactions, and the severity of symptoms can also differ.



Discover the signs, risks, and solutions to mold exposure. Learn how to identify and eliminate mold, taking charge of your environment to restore well-being and reclaim a healthier, mold-free life



Preventing mold growth after a water intrusion is crucial to maintaining a healthy indoor environment.




Detecting mold in your home involves a combination of visual inspection, recognizing musty odors, and sometimes using testing methods













THANK YOU
